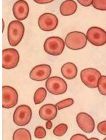
鉤蟲

症狀
 鉤蟲病
鉤蟲病 鉤蟲病
鉤蟲病病人早期可出現紅色高出皮膚的小丘疹,奇癢,抓破後易發炎,常常發生在足趾、手指之間,足趾,手腕與泥土接觸部位,俗稱“糞觸腳”、“打糞毒”,可持續3-5天。隨後可出現咳嗽、氣喘。成蟲在小腸內定居後,不斷從腸壁吸血,引起腸壁潰瘍出血,可出現貧血症狀,如面色、指甲蒼白,勞動後易氣急,心跳厲害,沒力氣。少數病人出現食慾怪癖,喜吃生米、泥土等。兒童嚴重感染後可影響生長發育。鉤蚴所致的症狀:
(1)皮膚損害:當蚴侵入皮膚時,局部有痒疹及匍行丘疹或小皰疹。由於抓癢可引起繼發感染,局部淋巴結亦可腫大。
(2)內臟損害:當蚴侵入血循環在體內移行時,可引起蠕動移行病及嗜酸粒細胞增多症。
幼蟲所致病變及症狀:
鉤蚴性皮炎:皮炎部位多見於與泥土接觸的足趾、手指間等皮膚較薄處,也可見於手、足的背部。
呼吸道症狀:鉤蚴移行至肺,穿破微血管進入肺泡時,可引起局部出血及炎性病變。患者可出現咳嗽、痰中帶血,並常伴有畏寒、發熱等全身症狀。重者可表現持續性乾咳和哮喘。若一次性大量感染鉤蚴,則有引起暴發性鉤蟲性哮喘的可能。成蟲引起的症狀:主要為失血性貧血,再加上由鉤蟲引起的食欲不振及消化不良而致營養缺乏,就更加重貧血的程度。故隨著疾病的發展,患兒常有面色蒼黃、皮膚乾粗、毛髮疏稀、失去光澤易於脫落。營養及發育均差,精神萎靡,表情淡漠,不願活動。有時煩躁不安、眩暈、心悸、氣短等貧血的症狀。發病初期先有食慾亢進,繼之食慾減退,時訴上腹部不適、有腹脹及疼痛感。有時腹瀉、有時便秘。
 鉤蟲病
鉤蟲病貧血:患者出現皮膚蠟黃、黏膜蒼白、眩暈、乏力,嚴重者作輕微活動都會引起心慌氣促。部分病人有面部及全身浮腫,尤以下肢為甚,以及胸腔積液、心包積液等貧血性心臟病的表現。肌肉鬆弛,反應遲鈍,最後完全喪失勞動能力。婦女則可引起停經、流產等。
嬰兒鉤蟲病:最常見的症狀為解柏油樣黑便,腹瀉、食慾減退等。體徵有皮膚、黏膜蒼白,心尖區可有收縮期雜音,肺偶可聞及羅音,肝、脾均有腫大等。此外,嬰兒鉤蟲病還有以下特徵:貧血嚴重,80%病例的紅細胞計數在200萬/mm3以下,血紅蛋白低於5g%,嗜酸性粒細胞的比例及直接計數值均有明顯增高;患兒發育極差,合併症多(如支氣管肺炎、腸出血等);病死率較高,在國外有報導鉤蟲引起的嚴重貧血及急性腸出血是造成1~5歲嬰幼兒最常見的死亡原因。1歲以內的嬰兒死亡率為4%,1~5歲幼兒死亡率可達7%,應引起高度重視。
臨床表現
 |  |
鉤蟲病是由於鉤蟲寄生於人體小腸所致的疾病。臨床以營養不良,貧血,胃腸功能紊亂為主要表現。傳染源為鉤蟲病患者和感染者,經皮膚接觸或生食蔬菜經口傳措,人群普遍易感,青壯年多見。本病屬中醫“黃腫病”,“疳黃”,“黃胖”範疇。
[臨床表現]
1.鉤蚴所致症狀(1)皮疹:呈丘疹、小皰疹。(2)呼吸系統症狀:可見咳嗽、聲啞、哮喘及痰中帶血。
2.成蟲引起的症狀(1)消化遭症狀:食慾亢進、上腹部引痛、後期有噁心、嘔吐、腹痛、腹瀉或便秘,有嗜食異物表現。(2)貧血。(3)循環系統症狀:因貧血程度而異,輕者心功能可正常,重者出現心功能不全的症狀及體徵。
[診斷]
鉤蟲
鉤蟲2。初起時足趾、足底紅腫,奇癢,皮膚出現丘疹,小皰疹,或有咳嗽、哮喘,痰中帶血症狀。
3.有典型的貧血,營養不良,胃腸功能紊亂症狀及異食表現。
4.糞便塗片或漂浮法可見鉤蟲卵。
5.紅細胞及血虹蛋白減少,嗜酸性粒細胞增高。
6.本病貧血應注意與其他原因的貧血相鑑別。
預防
(1)預防
①在農村高發地區,普查普治,統一服藥,定期複查,未愈病人重複服藥,徹底消滅感染源。
②加強糞便的管理,搞好廁所建設,不要隨地大便,糞便經無公害處理後再給植物施肥。
③加強衛生宣傳,使人們了解到鉤蟲病的感染方式,不要讓孩子赤腳去地里玩土,不許他們裸體嬉戲,要改變不穿死襠褲的壞習慣,減少鉤蟲幼蟲侵入皮膚的機會。
(2)治療
①有嚴重貧血和營養不良的孩子,暫不驅蟲,多吃些肉、蛋、豆製品、綠色蔬菜等,改善營養狀況。貧血患兒服用鐵劑;治療嚴重貧血,可以輸少量的鮮血。
②常用藥物:甲苯咪唑,每次服100毫升,每天服2次,連續服3天,治癒率99%,蟲卵轉陰率65%~90%。2歲以下小兒不用此藥。丙硫咪唑,成人400毫克,1次服下,10天后重複一次。12歲以下的孩子劑量減半。噻咪啶,每公斤體重10毫克基質,1次服下,連續服3天,蟲卵轉陰率95%。左鏇咪唑,每天每公斤體重3毫克,連服3天,蟲卵轉陰率80%~96%。
③鉤蟲幼蟲引起的皮炎,在感染後24小時內約90%的幼蟲停留在局部,將患處浸泡在50℃以上的熱水中,約經20分鐘,可將幼蟲殺死,並能止癢。
檢查
1.糞便蟲卵檢查。
2.便潛血檢查
可呈陽性。
3.血象
常有不同程度的貧血,屬於小細胞低色素性貧血。是酸性粒細胞可有增高。
4.X線胸片檢查
可出現肺紋理增多,散在片狀影,肺間質呈網狀結構等改變。
治療方法
 鉤蟲病
鉤蟲病一般療法:必須注意改善患兒的營養狀況,給高蛋白質、多維生素飲食。貧血者應補充鐵劑,並同時服用稀鹽酸每次10滴和維生素C以助鐵劑的吸收。貧血嚴重者應考慮少量輸血,每次25~50ml,或5~10ml/kg。出現嚴重心力衰竭者,先給毒毛鏇花子甙K。
驅蟲治療:驅鉤蟲藥物種類很多,但尚無較理想的藥物,需多次反覆治療才能根治。此外,農村鉤蟲病患者大多伴有蛔蟲等多種線蟲感染,故以採用廣譜驅腸線蟲藥為宜。如甲苯咪唑、噻嘧啶、丙硫咪唑、左鏇咪唑等,用法同治療蛔蟲病。國內鉤蟲病多系兩種鉤蟲混合感染,若用一種驅鉤蟲藥未驅盡時,可換用另一種藥物,藉以提高療效和減少副作用。在流行區應定期開展普查普治工作,一般宜選在冬、春季進行。驅鉤藥物的選擇,應根據鉤蟲蟲種及其他腸道寄生蟲的合併感染情況選擇高效、低毒的藥物。為了提高療效,尤其是驅美洲鉤蟲的療效,可採用交替用藥和聯合用藥。常用驅蟲藥物有:甲苯咪唑、丙硫咪唑、噻苯咪唑等藥,除對成蟲有殺滅驅蟲作用外,對蟲卵及幼蟲亦有抑制發育或殺滅作用。用噻苯咪唑配製15%軟膏局部塗敷,可治療鉤蚴性皮炎,若同時輔以透熱療法,效果更佳。將受染部位浸入53℃熱水中,持續20~30分鐘,有可能殺死皮下組織內移行的幼蟲。目前常用的驅鉤蟲藥物如下:
(1)甲苯咪唑(mebendazol):劑量每次100mg,每天2次,連服3天。驅鉤蟲的治癒率,因製品微粒大小而不同,微粒越小,療效越好,最高治癒率可達99%。一般蟲卵陰轉率為65%~90%。儘量不用於2歲以下嬰兒。近年來每次用200mg,1天2次,連服3~4天,蟲卵陰轉率為95%~100%。國內上海寄生蟲病研究所等8個單位聯合觀察,連服4天,陰轉率為98.8%,提出延長療程可提高療效。
(2)丙硫咪唑(albendazole):成人400mg頓服,10天后再重複給藥1次即可。12歲以下兒童用量減半。對十二指腸鉤蟲的療效優於美洲鉤蟲。
(3)左鏇咪唑(levamisole):對十二指腸鉤蟲療效較好。劑量3mg/kg·d,連服3天為一療程。蟲卵陰轉率為80%~96%,美洲鉤蟲為5%~25%。目前,一些發展中國家將此藥列為驅十二指腸鉤蟲的首選藥。
(4)噻嘧啶(pyrantelpamoate):劑量10mg基質/kg頓服,可連服3天,蟲卵陰轉率達95%以上;美洲鉤蟲為62.5%~80%。
 鉤蟲病
鉤蟲病此外,近來有報導伊維黴素(iverme-ctin)治療狗的重度鉤蟲感染,療效甚佳。在試管中能迅速殺死成蟲和感染期幼蟲。對臨床的套用於人體,尚得進一步研究。
(1)皮膚透熱法:當鉤蚴鑽進皮膚後,約在24小時內有90%停留在局部,故可用此法將蚴蟲殺死,達到止癢目的。方法:把手足發癢的部位浸泡在50℃以上熱水中,如感太燙,稍歇數秒鐘再泡,約30分鐘左右,或用毛巾放在50~60℃熱水中,取出後呈半乾狀態,使之緊貼在皮炎部位,每半分鐘換一次,連續10分鐘。
(2)局部塗2%~4%碘液,15%噻苯咪唑油膏,或5%硫黃爐甘石洗劑。
對症治療:鉤蟲病有貧血時應驅蟲同時補充鐵劑與高蛋白飲食。常用硫酸低鐵,每次0.3~0.6克,每日3次,服用鐵劑時間宜長,以補足組織內貯鐵。對少數口服鐵劑不能耐受者可給予肌肉注射鐵劑,如右鏇糖酐鐵,首次為50mg,以後每日或間日注射100mg,總量不超過2.5~3.0克,兩側臀部肌肉交替注射。嚴重貧血伴有胃酸缺乏可加服10%稀鹽酸或胃蛋白酶液。對臨產孕婦或貧血嚴重者,可在驅蟲前輸小量血或邊輸血邊驅蟲。
中醫治療:可採用艾卷或草紙卷點火,患部熏燙5分鐘,或用理髮電吹風吹3秒鐘,間歇7秒鐘,連續19秒種,可起局部消炎止癢作用。
 |  |
消化系統疾病(二)
| 消化系統疾病一直是影響人類生存質量的主要疾病,特別是消化系統腫瘤更是嚴重威脅人類健康。醫學統計數據表明,屬於消化系統腫瘤的肝癌和胃癌長年來一直位於我國腫瘤發病率的第二位和第三位。 |
消化系統疾病
| 消化系統疾病一直是影響人類生存質量的主要疾病,特別是消化系統腫瘤更是嚴重威脅人類健康。醫學統計數據表明,屬於消化系統腫瘤的肝癌和胃癌長年來一直位於我國腫瘤發病率的第二位和第三位。 | |||
| 胃炎 急性胃炎 急性胃腸炎 胃潰瘍 慢性萎縮性胃炎 慢性胃炎 慢性淺表性胃炎 消化性潰瘍 胃腸道脹氣 腸上皮化生 胃癌 胃痛 急性胃擴張 胃柿石症 胃黏膜脫垂症 胃下垂 胃泌素瘤 傾倒綜合徵 胃扭轉 小腸腫瘤 阿狄森氏病 | 大腸癌 直腸癌 肛門直腸損傷 結腸直腸腺瘤 克隆氏病 腸中風 急性腸炎 慢性腸炎 急性腸梗阻 急性腸胃炎 偽膜性腸炎 放射性腸炎 直腸陰道瘺 腸結核 缺血性腸病 闌尾炎 急性闌尾炎 蛔蟲病 蟯蟲病 鉤蟲病 | 先天性肛門閉鎖 肛門瘺管 肛裂 肛門梳硬結 肛門濕疹 肛門直腸先天畸形 直腸脫垂 肛門瘙癢 大便失禁 肛管直腸癌 便秘 器質性便秘 功能性便秘 結腸性便秘 妊娠便秘 產褥期便秘 小兒便秘 急性細菌性痢疾 小兒便血 胃原性腹瀉 | 感染性腹瀉 食物中毒 腺病毒胃腸炎 慢性肝炎 小兒肝炎 藥物性肝炎 酒精性肝炎 肝昏迷 肝功能衰竭 肝細胞凋亡 肝腫大 黃疸 老年肝硬化 肝纖維化 門靜脈高壓症 肝腎綜合徵 肝吸蟲病 肝功能檢查 肝穿刺 肝移植術 |
